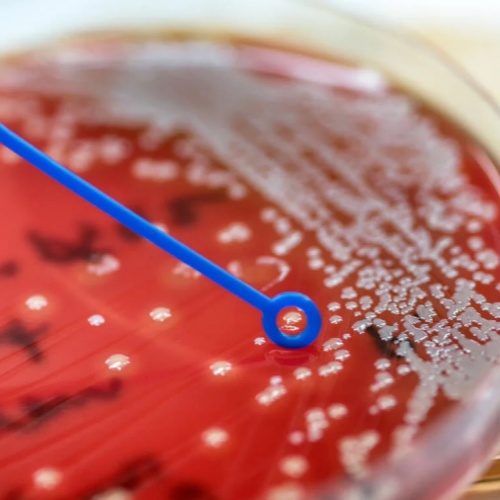

一、罕见的“口服碳青霉烯”正在接受审评
在抗生素领域,碳青霉烯类一直被视为对抗多重耐药菌的重要“后盾”药物,但这一类药物大多只能静脉给药,使用场景主要限于医院。如今,美国食品药品监督管理局(FDA)正在重新审评一种可口服的碳青霉烯类新药组合——苏洛培南乙酯(Sulopenem-Etzadroxil)/丙磺舒(Probenecid),拟用于单纯性尿路感染的治疗。
这也是该药物的“第二次闯关”,此前的上市申请未获通过,此次提交了新的临床数据后再次进入审评程序。
二、什么是苏洛培南?有何特别之处
苏洛培南最初由辉瑞日本研发,属于碳青霉烯类抗生素。体外研究显示,它对多种革兰阴性菌、革兰阳性菌以及厌氧菌均具有较广抗菌活性,其中包括对其他抗生素已产生耐药的病原体。
与亚胺培南等传统碳青霉烯类不同,苏洛培南的一个关键优势在于——可以口服使用。这为门诊治疗提供了新的可能,有望减少住院和静脉输液需求,对抗耐药感染的治疗模式具有潜在影响。
不过,截至目前,苏洛培南尚未获得正式上市批准。
三、为何要与丙磺舒联用
本次申报的并非单一成分,而是固定复方制剂:苏洛培南乙酯 + 丙磺舒。
其中涉及两个关键药理设计:
首先,苏洛培南以脂溶性酯类前药(S-构型)形式给药,以提高口服生物利用度。进入体内后,经酯酶水解释放出活性药物。
其次,加入丙磺舒是为了“延长药物在体内的时间”。丙磺舒通过抑制肾脏中的有机阴离子转运体1型(OAT1),减少苏洛培南的肾脏清除,从而:
延长半衰期;
提高血药浓度;
增强整体抗菌暴露量。
这种“前药 + 肾排泄抑制剂”的策略,在抗感染药物开发中并不常见,体现了对药代动力学优化的思路。
四、针对的是哪类感染?
此次申请的适应证为:成人女性单纯性尿路感染(uUTI)。
单纯性尿路感染是临床最常见的细菌感染之一,常见致病菌为大肠杆菌。随着耐药率上升,传统口服抗生素(如喹诺酮类、β-内酰胺类)疗效面临挑战,因此对新的口服抗菌药物存在实际需求。
五、关键临床研究结果
本次重新提交的申请包含多项临床研究数据,主要来自 REASSURE 以及 SURE 1、2、3 研究。这些研究显示该药总体耐受性良好。
在疗效方面:
在 REASSURE 研究 中,口服苏洛培南与阿莫西林/克拉维酸进行比较,用于治疗成人女性尿路感染。结果显示,苏洛培南在临床疗效和微生物学清除率方面均显著优于对照方案。
在 SURE 1 研究 中,口服苏洛培南与口服环丙沙星比较,同样用于女性尿路感染患者。结果也显示苏洛培南在疗效方面优于对照治疗。
这些结果支持其在耐药菌比例升高背景下,作为口服治疗新选择的潜力。
六、目前处于什么阶段
企业 Iterum Therapeutics 于 2024 年 4 月底向 FDA 递交了上市申请。公司预计,FDA 最迟可能在 2024 年第四季度对是否批准做出决定。
如果获批,这将是少数可口服的碳青霉烯类抗生素之一,可能改变部分尿路感染的门诊治疗策略。
七、需要理性看待的几点
虽然这一进展令人关注,但仍需注意:
碳青霉烯类属于重要的“保留类”抗生素,若广泛用于门诊,必须严格遵循抗菌药物管理原则,避免耐药性进一步加剧;
当前数据主要集中在特定人群和适应证,真实世界应用效果仍需进一步观察;
长期安全性和对耐药生态的影响仍需持续监测。
总结
苏洛培南乙酯/丙磺舒作为一种可口服的碳青霉烯类候选药物,为单纯性尿路感染的治疗提供了新的研发方向。其核心价值在于:在保持碳青霉烯类广谱抗菌活性的同时,实现口服给药的可行性。如果顺利获批,或将成为抗感染治疗格局中的一个重要补充,但其使用仍需建立在严格的合理用药基础之上。